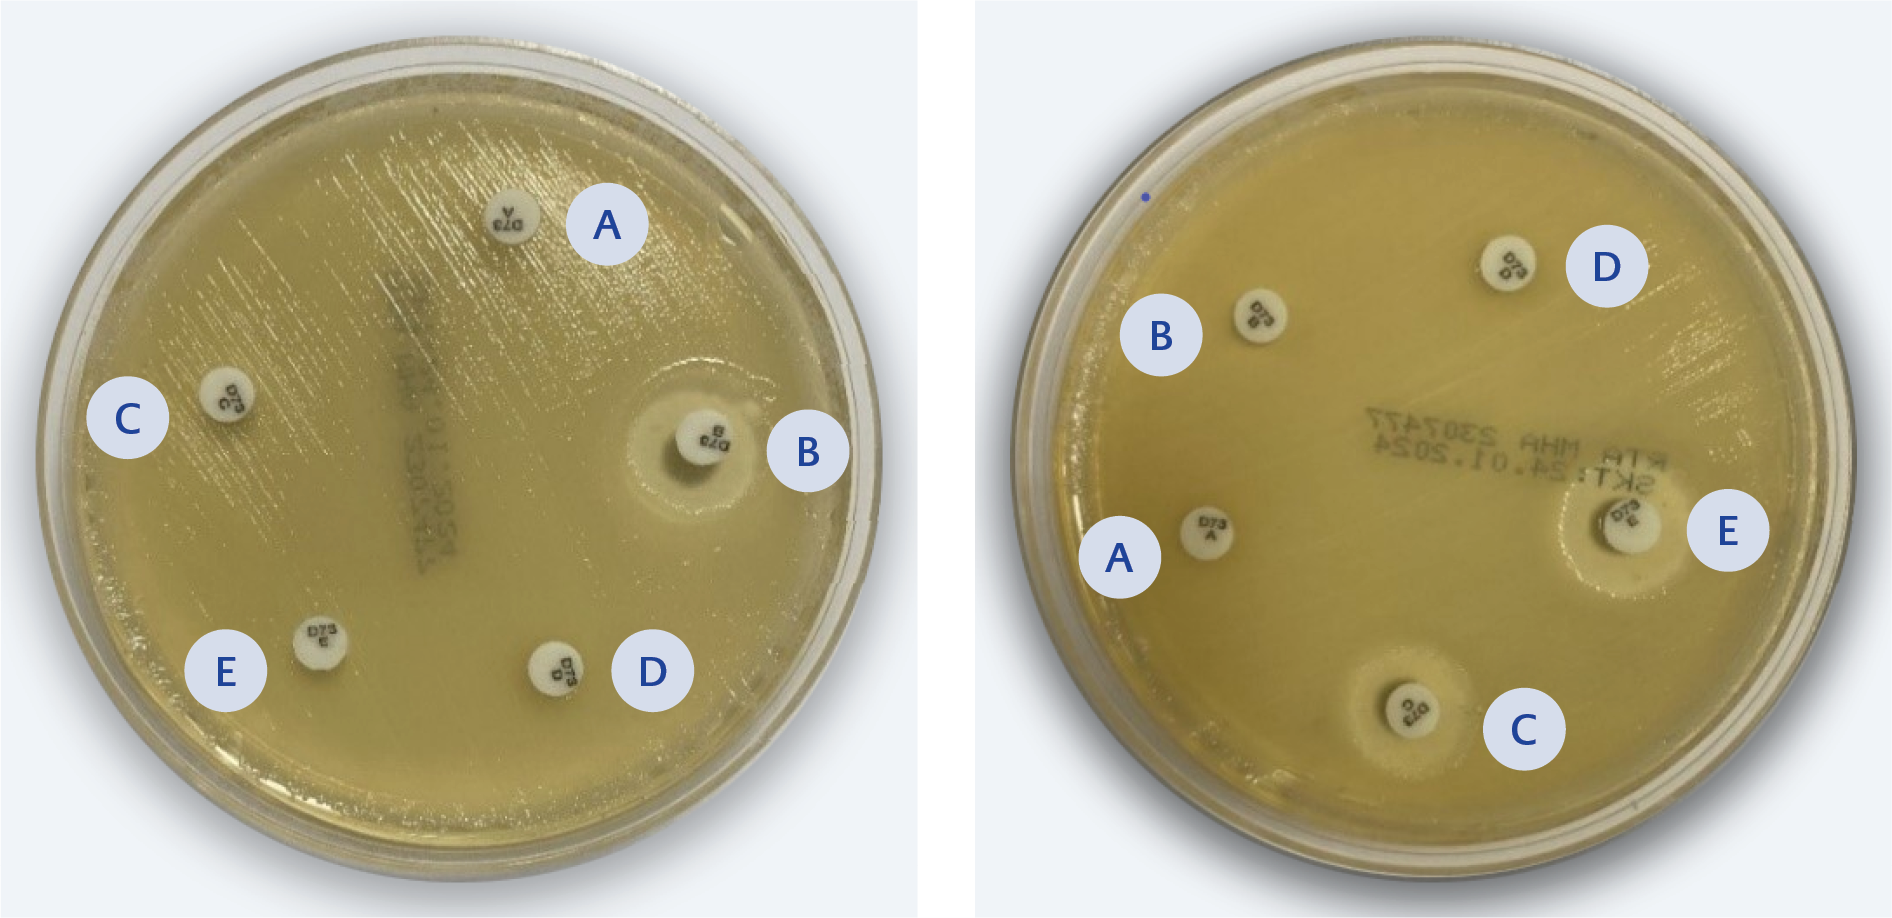

Introduction
Infections caused by carbapenem-resistant Gram-negative bacteria have become a significant global public health problem due to the growing burden of antimicrobial resistance. According to predictive analyses, approximately 4.95 million deaths were associated with antibiotic resistance in 2019 (1). The World Health Organization (WHO) priority pathogen list identifies carbapenem-resistant Klebsiella pneumoniae as a critical pathogen of public health importance, guiding research, development, and strategies to prevent and control antimicrobial resistance (2).
Carbapenem resistance has also been increasing in Türkiye, consistent with global trends. According to WHO European antimicrobial resistance surveillance report published in 2022, carbapenem resistance in K. pneumoniae exceeded 25% in 30% of participating countries; in Türkiye, the reported resistance rate was 48.2% in 2020 (3). Globally, the most prevalent carbapenemase among Enterobacterales is K. pneumoniae carbapenemase (KPC); oxacillinase-48 (OXA-48)-like carbapenemases are rare in the United States but more common in Mediterranean countries (4). In Türkiye, OXA-48 is the most commonly reported carbapenemase type (5).
Cefiderocol is a novel siderophore cephalosporin developed for the treatment of infections caused by carbapenem-resistant Gram-negative bacteria. It crosses the bacterial outer membrane through iron transport channels and enters the periplasmic space (6). The United States Food and Drug Administration (FDA) approved cefiderocol in November 2019 for the treatment of complicated urinary tract infections and in September 2020 for hospital-acquired pneumonia and ventilator-associated bacterial pneumonia. Similarly, the European Medicines Agency (EMA) granted approval in April 2020 for the treatment of infections caused by Gram-negative bacilli in adults with limited therapeutic options (7). To date, cefiderocol has not been approved for clinical use in Türkiye.
This study aimed to determine cefiderocol susceptibility and carbapenemase production in CRE isolates collected from Çanakkale and Edirne. Additionally, we evaluated the relationship between carbapenemase type and cefiderocol susceptibility and statistically compared the results between the two centers. By presenting regional susceptibility data from the Western Marmara Region, this study provides preliminary information on the potential benefits of cefiderocol, an antimicrobial agent not yet approved or commercially available in Türkiye.
Materials and Methods
Carbapenem-resistant Enterobacterales isolates obtained between 2021 and 2022 from blood, respiratory tract, and urine samples collected from inpatient wards and intensive care units of Çanakkale Onsekiz Mart University and Edirne Sultan Murat I State Hospital were included in the study. The isolates were identified through routine microbiological methods, preserved in glycerol-enriched media, and stored at -80°C. The first CRE isolate obtained from each patient was included in the analysis. Carbapenem resistance was defined as resistance to ertapenem, imipenem, and meropenem according to European Committee on Antimicrobial Susceptibility Testing (EUCAST) version 14.0 guidelines (8).
Identification and antimicrobial susceptibility testing of the isolates were performed using BD Phoenix M50 (Becton Dickinson, Sparks, MD, USA) in Çanakkale and VITEK-2 (BioMérieux, Marcy-l’Étoile, France) in Edirne.
According to EUCAST v14.0, the zone diameter breakpoint for cefiderocol in Enterobacterales is 23 mm, and the area of technical uncertainty (ATU) is defined as 21–23 mm. The minimum inhibitory concentration (MIC) breakpoint for susceptibility is 2 mg/L (9). According to CLSI 33rd edition guidelines, isolates with a zone diameter of ≤8 mm are classified as resistant, 9–15 mm as intermediate, and ≥16 mm as susceptible; corresponding MIC breakpoints are ≥16 mg/L for resistance, 8 mg/L for intermediate susceptibility, and ≤4 mg/L for susceptibility (10).
Carbapenem resistance of all isolates was confirmed using ertapenem (10 µg), imipenem (10 µg), and meropenem (10 µg) disks. Cefiderocol susceptibility testing was performed by disk diffusion using a 30 µg cefiderocol disk in accordance with EUCAST v14.0. Isolates classified as resistant and within the ATU were further analyzed by MIC testing using the Liofilchem ComASP® kit (Liofilchem, Roseto degli Abruzzi, Italy). The selection process for isolates subjected to MIC testing is illustrated in Figure 1. Final cefiderocol susceptibility interpretations were based on MIC results.
Carbapenemase production was investigated in resistant and ATU isolates using the MAST Disc Combi Carba Plus kit (Mast Group, Bootle, United Kingdom) by the combination disk method. Detection of carbapenemase types was performed according to the manufacturer’s instructions. Escherichia coli ATCC 25922 was used as the quality control strain.
Statistical analyses were performed using SPSS version 21 (IBM Corp., Armonk, NY, USA). Fisher’s exact test was used to compare cefiderocol susceptibility rates between institutions. The association between carbapenemase type and cefiderocol susceptibility was evaluated using the Pearson Chi-square test with Bonferroni correction. A p-value <0.05 was considered statistically significant.
This study was approved by the Çanakkale Onsekiz Mart University Clinical Research Ethics Committee on November 16, 2022 with the decision number 2022/14–23.
Results
A total of 120 CRE isolates were included in the study; 100 isolates from Çanakkale (n=76 K. pneumoniae, n=14 Serratia marcescens, n=7 E. coli, n=2 Enterobacter cloacae, n=1 Citrobacter freundii) and 20 isolates from Edirne (n=20 K. pneumoniae).
According to disk diffusion test results, in Çanakkale, 89 (89%) isolates were susceptible to cefiderocol, 6 (6%) were resistant, and 5 (5%) were within the ATU. In Edirne, 17 (85%) isolates were susceptible, 3 (15%) isolates were resistant, with no isolates classified within the ATU (Table 1).

Table 2. Characteristics of isolates detected as ATU and interpretation of cefiderocol susceptibility test results.
A total of 14 isolates, consisting of those classified as resistant and those within the ATU category, were further analyzed by MIC testing. Based on the MIC results, all nine isolates initially classified as resistant by disk diffusion remained resistant, whereas all five ATU isolates were found to be susceptible (Table 2). Accordingly, cefiderocol susceptibility was 94% (n=94) in Çanakkale and 85% (n=17) in Edirne. When all isolates were considered together, the overall cefiderocol susceptibility rate in the Western Marmara region was 92.5% (n=111) according to EUCAST v14.0.
According to CLSI guidelines, in Çanakkale, 1 (1%) isolate was classified as intermediate based on zone diameter, while 99 (99%) isolates were classified as susceptible. The isolate identified as intermediate was also classified as intermediate based on its MIC value. In Edirne, all isolates were susceptible to cefiderocol based on zone diameter and 1 (5%) isolate intermadiate based on its MIC value. Thus, according to CLSI guidelines, cefiderocol susceptibility was 98% in Çanakkale and 95% in Edirne, with an overall susceptibility rate of 97.5% (n=117) in the Western Marmara region (Table 3).
When susceptibility rates were evaluated by species, all isolates of C. freundii (n=1), E. cloacae (n=2), and E. coli (n=7) from Çanakkale showed 100% susceptibility. Susceptibility rates were 92.8% (n=13) for S. marcescens and 93.4% (n=71) for K. pneumoniae in Çanakkale. In Edirne, K. pneumoniae isolates demonstrated a susceptibility rate of 85% (n=17). No statistically significant difference in cefiderocol susceptibility was observed between K. pneumoniae isolates from the two centers (p=0.35).
Figure 2. 2a) MBL positive K. pneumoniae (Inhibition zone diameter difference between disc B and disc A was ≥5 mm and <5 mm difference between disc C or disc D and disc A). 2b) KPC positive K. pneumoniae (Inhibition zone diameter difference between disc C and disc A was ≥5 mm and <5 mm difference between disc B or disc D and disc A). Kit composition: A set of cartridges with paper discs containing A – penem; B – penem + MBL inhibitor; C – penem + KPC inhibitor; D – penem + AmpC inhibitor; E – Temocillin + MBL inhibitor – each with an inert carrier.
Carbapenemase typing was performed on 98 randomly selected isolates (78 from Çanakkale, 20 from Edirne), including the resistant isolates and those within the ATU category. Among the 78 isolates from Çanakkale, 46 (59%) were identified as KPC producers (K. pneumoniae n=40, E. coli n=5, C. freundii n=1), 16 (20.5%) as OXA-48 producers (S. marcescens n=10, K. pneumoniae n=5, E. cloacae n=1), and 13 (16.6%) as MBL producers (K. pneumoniae n=7, S. marcescens n=4, E. coli n=1, E. cloacae n=1). No carbapenemase type was identified in three isolates, and AmpC β-lactamase production was not detected in any isolate. Results for K. pneumoniae isolates identified as KPC- or MBL-positive are presented in Figure 2. Among the 20 K. pneumoniae isolates from Edirne, 15 (75%) were OXA-48 producers, 3 (15%) were MBL producers, and 2 (10%) were KPC producers (Table 4).
Of the nine isolates resistant to cefiderocol, 5 (56%) produced KPC, while 4 (44%) produced MBL. Cefiderocol resistance was observed in 4 of 16 (25%) MBL-producing isolates and 5 of 48 (10%) KPC-producing isolates. All OXA-48-producing isolates were susceptible to cefiderocol.

Table 5. Cefiderocol susceptibility rates and 95% confidence intervals according to carbapenemase type.
Among the 98 isolates evaluated, cefiderocol susceptibility rates were 90% for KPC producers, 100% for OXA-48 producers, and 75% for MBL producers. The 95% confidence intervals (CIs) for these rates were 77.4%–96.0% for KPC, 88.8%–100% for OXA-48, and 50.5%–89.8% for MBL producers (Table 5). OXA-48-producing isolates were statistically significantly more susceptible to cefiderocol than MBL-producing isolates (p<0.001).
Discussion
Cefiderocol is a novel siderophore cephalosporin developed for the treatment of carbapenem-resistant Gram-negative bacteria and has demonstrated potent in vitro activity against CRE, Acinetobacter baumannii, and Pseudomonas aeruginosa, with low MIC90 values reported in previous studies (11). In the present study, overall cefiderocol susceptibility in the Western Marmara region was 92.5% according to EUCAST and 97.5% according to CLSI, indicating high activity against CRE isolates.
Reported cefiderocol susceptibility rates for Enterobacterales vary across studies and regions. Morris et al. (12) reported an overall susceptibility rate of 67% according to EUCAST, with lower rates observed for K. pneumoniae (62%) than for E. coli (83%). Similarly, Mushtaq et al. (13) reported susceptibility rates of 78.2% based on EUCAST criteria and 92.1% according to CLSI. In a study conducted in Türkiye by Mirza et al. (14) in 2022, cefiderocol susceptibility among 55 CRE isolates was 74.5% by EUCAST and 98.3% by CLSI. According to EUCAST, susceptibility rates were 75% for K. pneumoniae and 73.3% for E. coli, while CLSI criteria yielded rates of 95% and 100%, respectively. Another study from Türkiye, published in 2023, included 254 K. pneumoniae isolates and reported cefiderocol susceptibility rates of 74% by EUCAST and 93% by CLSI using disk diffusion testing, with 19% of the isolates categorized within the ATU range according to EUCAST (15). In a separate study including 133 carbapenemase-producing Enterobacterales isolates, all isolates were reported as susceptible to cefiderocol by disk diffusion testing (16).
Compared with these reports, cefiderocol susceptibility rates observed in both Çanakkale and Edirne were higher. Evidence from in vitro and clinical studies suggests that cefiderocol use may lead to progressive reductions in susceptibility among carbapenem-resistant CRE isolates (17). In vitro exposure of K. pneumoniae, E. coli, and A. baumannii strains to increasing concentrations of cefiderocol has been shown to result in MIC values up to 512-fold higher (18). The higher susceptibility observed in our study may therefore be related to the fact that cefiderocol is not yet in clinical use in Türkiye, and therefore isolates that have developed resistance during treatment are unlikely to be encountered. Furthermore, the limited number of studies investigating cefiderocol susceptibility in CRE isolates in Türkiye may contribute to the observed differences.
Interpretation challenges related to cefiderocol susceptibility testing have been highlighted previously. Brauncajs et al. (19) emphasized difficulties associated with isolates falling within ATU and noted discrepancies between disk diffusion and MIC-based results. Similarly, in our study, isolates falling within the ATU category complicated susceptibility interpretation, and notable differences were observed between EUCAST and CLSI criteria. We believe that further research is necessary to minimize guideline-based variability and clarify the clinical significance of ATU classified isolates.
Globally, KPC is the most prevalent carbapenemase among Enterobacterales, whereas OXA-48-like carbapenemases are more commonly reported in Mediterranean countries, including Türkiye (4,5). While national data indicate OXA-48 as the predominant carbapenemase type, our study identified a higher prevalence of KPC-producing isolates in Çanakkale, possibly reflecting local epidemiological patterns or hospital-specific outbreaks. In Edirne, the predominance of OXA-48-producing isolates was consistent with previously published data.
Differences in cefiderocol susceptibility according to carbapenemase type have also been reported. A meta-analysis by Wang et al. (20) demonstrated higher cefiderocol MIC values among New Delhi metallo-β-lactamase (NDM) producing isolates compared with other carbapenemase producers. Similarly, Mirza et al. (14) reported significantly lower susceptibility rates among NDM-producing isolates compared with OXA-48 producers. Consistent with these findings, our analysis revealed that OXA-48-producing isolates were significantly more susceptible to cefiderocol than MBL-producing isolates.
In conclusion, this study provides region-specific data on cefiderocol susceptibility among CRE isolates in the Western Marmara region. Isolates producing OXA-48 exhibited significantly higher susceptibility to cefiderocol compared with MBL-producing strains, highlighting the potential influence of carbapenemase type on cefiderocol activity. Although cefiderocol is not yet commercially available in Türkiye, these findings provide preliminary evidence of its potential as a therapeutic option for CRE infections and may inform future surveillance studies and therapeutic decision-making as access to this agent expands.




